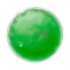
heat pack

Спасибо! Ваше сообщение отправлено
Ошибка! Попробуйте ещё раз!
Расскажите нам про: задачу, тираж, бюджет - подберем в течение дня концепцию подарков БЕСПЛАТНО!

адрес
г. Брест, ул. Советская 67-61 Республика Беларусь
электронная почта
zakaz@new-ton.org
Россия
+7 910 761 09 02
Беларусь
+375 33 607 00 70
 Напишите нам в Telegram
Напишите нам в Telegram
 Напишите нам в Whatsapp
Напишите нам в Whatsapp
 Напишите нам в Viber
Напишите нам в Viber
 Напишите нам в Max
Напишите нам в Max
1.24 €
4.92 BYN
Без НДС: 4.10 BYN
144.34 ₽
Без НДС: 118.31 ₽
минимальный заказ от 250€
*Без учета НДС
На БОЛЬШИЕ тиражи даем БОЛЬШИЕ скидки!